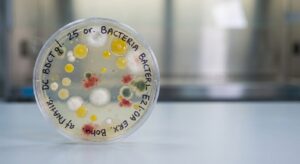
Bakterijų kolonijos biologinių įrenginių pavyzdyje

Bakterijos lauko tualetams kvapui naikinti | Patarimai
Kaip panaudoti bakterijas lauko tualetams ir panaikinti nemalonų kvapą Lauko tualetai dažnai kankinami nemalonių kvapų, tačiau tinkamai panaudojus bakterijas lauko tualetams nemaloniam kvapui panaikinti, šią problemą galima veiksmingai išspręsti. Šiame